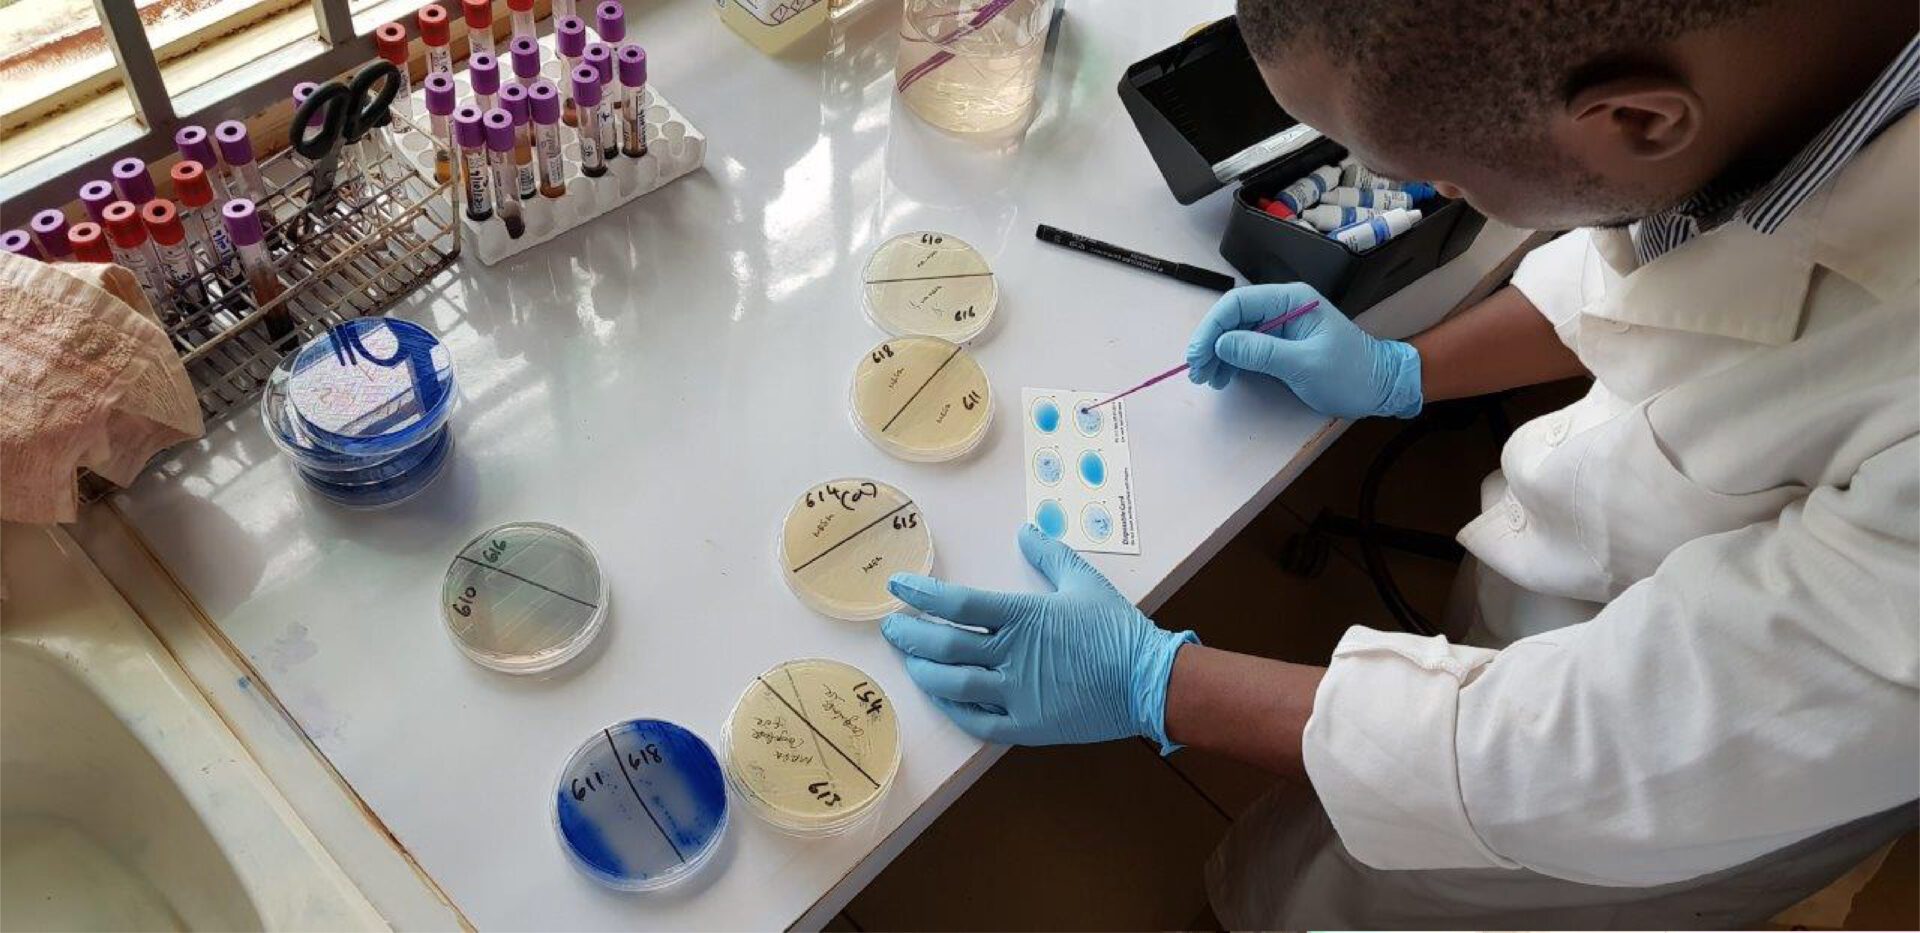

Desde la secretaría de Agricultura, Ganadería y Pesca, se informó que la medida responde a un proceso de trabajo técnico consensuado, entre los especialistas del sector público y el privado, basado en la evidencia científica, los avances tecnológicos, las ciencias regulatorias y orientado a impulsar la innovación, la inversión y la competitividad del agro.
La comunicación oficial destaca que la flamante Resolución 255/2026, actualizó y simplificó la normativa anterior (Resolución 763/11), marco referente a Organismos Genéticamente Modificados de uso agropecuario, agroalimentario y agroindustrial tanto con fines de experimentación como comerciales, para el fortalecimiento de un marco regulatorio claro, que mejora la previsibilidad de las inversiones, acompañando los avances científicos y tecnológicos del sector.
Argentina ocupa una posición de liderazgo en la regulación y el acompañamiento de los avances y desarrollos OGMs para el sector agropecuario desde los inicios de estas actividades en el año 1991. Esta regulación tiene por fin garantizar que los OGMs pertenecientes a especies de uso agropecuario o que potencialmente pudieran emplearse en un contexto agropecuario, sean seguros tanto en las etapas experimentales como en la comercialización, sin afectar las exportaciones.
Desde la repartición oficial destacaron que "desde 1996 a la actualidad se llevaron adelante 134 aprobaciones de productos genéticamente modificados por parte del Estado Nacional. De ese total, 38 autorizaciones se realizaron desde el inicio de la gestión del actual Gobierno, lo que implica un récord de casi el 28% de todos los desarrollos de este tipo autorizados comercialmente por el país en los últimos 30 años.
































































Envía tu comentario